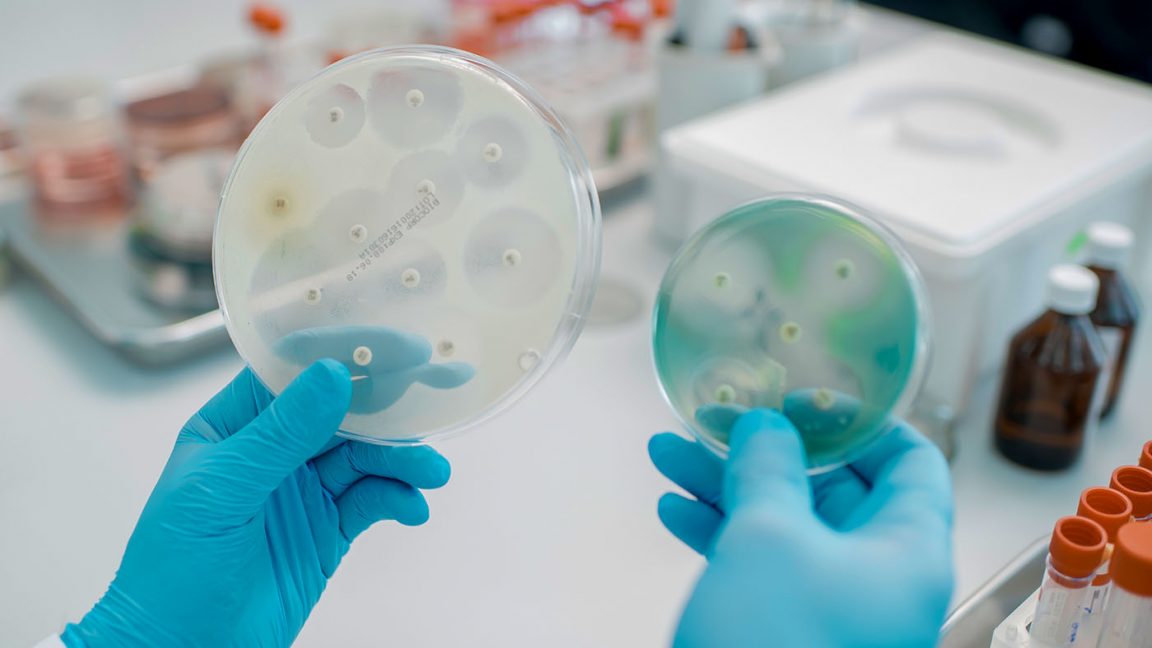

Устойчивость к противомикробным препаратам является непосредственной причиной 1,3 миллиона смертей и одним из факторов еще пяти миллионов смертельных случаев каждый год. При этом существует множество способов борьбы с этой угрозой, в том числе меры гигиены и санитарии, вакцинация и усилия по предотвращению чрезмерного или неправильного использования противомикробных препаратов.
Противомикробные препараты, в том числе антибиотики, противовирусные, противогрибковые и противопаразитарные средства, значительно увеличили среднюю продолжительность жизни с момента их открытия. Они помогают миллионам людей каждый день, однако в результате УПП лекарственные средства утрачивают свою эффективность.
УПП возникает в результате постепенной мутации бактерий, вирусов, грибков и паразитов и утраты ими восприимчивости к лекарственным препаратам, что затрудняет лечение инфекций и повышает риски распространения, тяжелого течения и летального исхода болезней. Так, незначительная травма, рутинная операция или обычная инфекция могут неожиданно перерасти в опасную для жизни ситуацию, привести к длительной болезни, утрате трудоспособности и даже смертельному исходу.
«Устойчивость к противомикробным препаратам ставит под угрозу достигнутый за последнее столетие прогресс в области медицины и может вернуть нас в эпоху до появления антибиотиков, когда инфекции, которые сегодня поддаются лечению, могли быть равносильны смертному приговору, – заявил Генеральный директор ВОЗ Тедрос Адханом Гебрейесус. – Эта проблема создает угрозу для всех стран независимо от уровня дохода, поэтому крайне необходимы неотложные решительные, быстрые и хорошо скоординированные глобальные ответные меры».
Устойчивость к противомикробным препаратам развивается со временем естественным образом, обычно в результате генетических мутаций. Несколько факторов ускоряют появление и распространение лекарственной резистентности, при этом ключевыми из них являются использование антибиотиков в отсутствие необходимости, чрезмерное назначение антибиотиков медицинскими работниками и незавершенные курсы лечения.
Использование антибиотиков в сельском хозяйстве для профилактики заболеваний и стимулирования роста животных может привести к образованию устойчивых штаммов, которые могут передаваться человеку.
Кроме того, неадекватные санитарно-гигиенические условия в медицинских учреждениях и сельхоз предприятиях способствуют распространению устойчивых микроорганизмов. При этом глобальная торговля и международные путешествия позволяют патогенам распространяться по всему миру.
Рост заболеваемости устойчивыми к лечению инфекциями имеет серьезные последствия для индивидуального и общественного здоровья, а также влияет на продовольственную безопасность. Помимо этого, УПП наносит значительный урон экономике и системам здравоохранения стран, поскольку уменьшает трудоспособность пациентов и ухаживающих за ними лиц в связи с удлинением сроков госпитализации и потребностью в более дорогостоящих и интенсивных видах терапии.
Без эффективных инструментов профилактики и надлежащего лечения лекарственно устойчивых инфекций и расширения доступа к существующим и новым качественным противомикробным препаратам число людей, не излечивающихся или умирающих от инфекций, будет расти. Более рискованными станут такие медицинские вмешательства, как хирургические операции, в том числе кесарево сечение или эндопротезирование тазобедренного сустава, химиотерапия онкологических заболеваний и трансплантация органов.
Эффективным инструментом борьбы с заболеваемостью является снижение потребности в противомикробных препаратах путем укрепления систем здравоохранения за счет всеобщего охвата услугами и приоритетного внимания профилактике, иммунизации и программам водоснабжения, санитарии и гигиены.